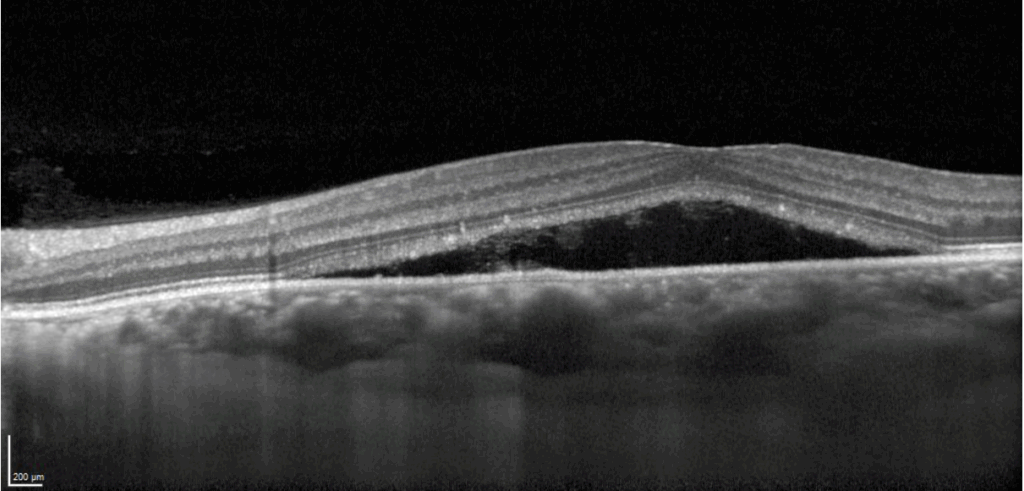

Coriorretinopatía central serosa aguda
Retinografía color en la que se observa una retina con escasa teselación en el polo posterior, y destaca una ampolla transparente de fluido subretiniano a nivel macular.
En la angiografía fluoresceínica se observa una arquitectura vascular normal. Característico de esta patología, se aprecia un punto de fuga del colorante nasal a la mácula con tinción en mancha de tinta.
El verde indocianina, muestra cierta hipocianescencia probablemente secundaria a la compresión de los vasos paquicoroideos. Se observa el mismo punto de fuga que veíamos en la fluoresceina. Recordemos que no siempre se observa el punto de fuga en la indocianina, depende del tamaño del punto de fuga. Por último, destacar los espacios hipocianescentes secundarios a los desprendimientos de EPR
La OCT muestra un desprendimiento neurosensorial de la retina. Destacamos una elongación de los fotorreceptores, hacia el lado nasal de la fóvea se aprecia contenido hiperreflectivo en el espacio subretiniano, cierta excavación sobre el techo de la elongación de los fotorreceptores. Y coincidiendo con el punto de fuga, detectamos la presencia de un vaso coroideo de gran dimensión comprimiendo la coriocapilar.
Descripción
Coriorretinopatía central serosa aguda. La coroidopatía central serosa aguda (CSCR) es una patología ocular caracterizada por la acumulación de fluido seroso entre el epitelio pigmentario de la retina (EPR) y la retina neurosensorial, lo cual provoca un desprendimiento seroso de la mácula. Este trastorno se presenta predominantemente en hombres jóvenes y de mediana edad y está asociado con factores de riesgo como el estrés, el uso de corticosteroides y un perfil de personalidad tipo A. La etiología de la CSCR no está completamente comprendida, pero se cree que la hiperpermeabilidad de la coroides juega un papel crucial, facilitada por la disfunción de la barrera hematorretiniana. Los pacientes típicamente presentan una visión borrosa, metamorfopsias y micropsias. El diagnóstico se confirma mediante técnicas de imagen como la tomografía de coherencia óptica (OCT) y la angiografía con fluoresceína, que muestran el desprendimiento seroso y la fuga de fluido subretiniano. Aunque la CSCR puede resolver espontáneamente en muchos casos, el tratamiento puede incluir la fotocoagulación con láser o la terapia fotodinámica (TFD), o el láser subumbral para casos crónicos o recurrentes.